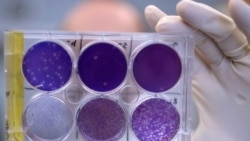
Virus zike analizira se na Medicinskom fakultetu univerziteta Vašington u Sent Luisu u Mizuriju.

Testiranje vakcine za novi Vuhan coronavirus moglo bi da počne u naredna tri mjeseca, izjavio je direktor Nacionalnog instituta za alergije i infektivne bolesti, Entoni Fauči.
To je - brzo.
Bilo je potrebno 20 mjeseci da vakcina za teški aktuni respiratorni sindrom - SARS - bude spremna za kliničko testiranje.
To ne znači da ćete za tri mjeseca moći da stanete u red i dobijete vakcinu. Naučnici moraju da testiraju koliko je sigurna i efikasna, a za to će biti potrebno još nekoliko mjeseci.
Međutim, vrijeme potrebno da se od izbijanja zaraze dođe do moguće vakcine je kraće nego ikada, djelimično zahvaljujući novoj vrsti vakcine.
Tehnologija iz 18. veka
Od kada je Edvard Džener razvio prvu vakcinu u 18. vijeku, onu protiv malih boginja, vakcine u suštini funkcionišu na isti način. Pacijenti se vakcinišu oslabljenim ili ubijenim mikrobom ili nekim od njegovih ključnih proteina. Imuni sistem tijela reaguje na mikrob i sljedeći put kada se virus ili bakterija pojave, tijelo može da ih prepozna i neutrališe.
Kompanije uzgajaju mikrobe ili njihove dijelove u jajima ili epruvetama sa živim ćelijama. Da bi se proizvelo dovoljno komponenata za milione vakcine, potrebna je godina ili više rada u velikim fabrikama.
Naučnici su proteklih godina, međutim, počeli da istražuju drugačiji pristup. Umjesto da se ubrizga dio samog virusa ili bakterije, eksperimentalne vakcine sadrže genetski nacrt dijelova virusa ili bakterije, a onda ih proizvodi samo tijelo pacijenta.
Aktivni sastojak u tim vakcinama je DNK ili RNK, genetska instrukcija za izgradnju proteina.
“Više vam ni ne treba virus" - kaže profesor molekularne mikrobiologije Endru Pekoš sa Blumberg škole javnog zdravlja pri Univerzitetu Džons Hopkins. Sve što je naučnicima potrebno je genetski kod virusa. "A on je postao dostupan u ranim danima izbijanja ove zaraze", dodaje on.
Dizajn vakcine za tri sata
Kineski naučnici su prvi objavili slučajeve neobične upale pluća 31. decembra 2019. Do 11. januara, izolovali su novi koronavirus i objavili njegov kompletan genom.
Sa sastavom novog virusa u ruci, kompanija Inovio Farmasjutikals napravila je vakcinu za tri sata. Proizvodnja je počela već sljedećeg dana.
“To je dosta nevjerovatno, zar ne?", kaže Kejt Broderik, šef za istraživanja i razvoj u kompaniji Inovio.
Vakcina na kojoj radi Inovio je zasnovana na DNK. Dvije druge kompanije Moderna i KjurVek rade na nečemu što se zove informaciona RNK ili "mesindžer RNK". Ako je DNK nacrt proteina, mRNA je radna kopija koja se nosi na samu lokaciju gradnje, i nju mašinerija našeg tijela koristi da nacrt pretvori u finalni proizvod.
Obje metode mogu lako da se adaptiraju kada se pojavi nova boleset. Inovio ima vakcine u kliničkom testiranju za Bliskoistočni respiratorni sindrom, koji izaziva drugi koronavirus. Kompanija takođe radi na vakcinama za ziku, ebolu, lasu, HIV i druge bolesti.
Lijekovi bazirani na DNK ili RNK imaju potencijal i za liječenje raka. Inovio, Moderna i KjurVek su među kompanijama koje razvijaju genetske terapije za rak grlića materice, pluća, kože, prostate i druge vrste kancera.
Tehnologija postoji već oko 20 godina, kaže Broderik, ali je značajan napredak ostvaren proteklih godina. Na tržištu još nema lijekova za ljude na osnovu DNK ili RNK, ali ima nekoliko za životinje, uključujući lijekove za virus Zapadnog Nila kod konja, melanom kod pasa i genetsku terapiju koja proizvodi hormon rasta kod svinja.
Klinička testiranja
Dok DNK ili RNK vakcine mogu da se brzo naprave - potrebno je vrijeme da se one testiraju, ističe Broderik koja dodaje da je to neophodno. Poslije proizvodnje, testovi sigurnosti koji se sprovode na životinjama trajaće nekoliko mjeseci. Onda počinje prva faza kliničkog ispitivanja. Testiranje sigurnosti na ljudima koji se dobrovoljno prijave za ispitivanja trajaće tri mjeseca, kaže Entoni Fauči.
Poslije toga, "neke vakcine mogu da budu hitno odobrene za upotrebu u ovakvim epidemijama", kaže Pekoš iz bolnice Džons Hopkins.
Kada se dokaže da je vakcina sigurna, naučnici moraju da dokažu i da je efikasna. Za to će biti potrebno još nekoliko mjeseci.
Do tada, zaraza bi mogla da bude završena. To se dogodilo sa SARS-om. Do trenutka kada je eksperimentalna vakcina prošla kroz prvu fazu testiranja, dobri, stari karantin je zaustavio širenje virusa.
“To je uvijek problem koji imamo kod ovakih zaraza", kaže Pekoš. Kada se završi epidemija, "interesovanje za razvoj vakcine opada kao i svijest o potrebi da se razvije vakcina. Vakcine onda završe u nekoj nedođiji gdje se delimično proučavaju ali nikada ne dovedu do same proizvodnje."
A onda izbije nova zaraza.
“Mogli smo da se mnogo bolje pripremimo za ovu epidemiju da smo samo doveli do kraja rad na vakcini za SARS", ističe ovaj naučnik.
To je posao za vladine agencije, dodaje, "da bismo imali podatke o tome koliko je dobra neka vakcina prije nego što nam zaista bude potrebna."